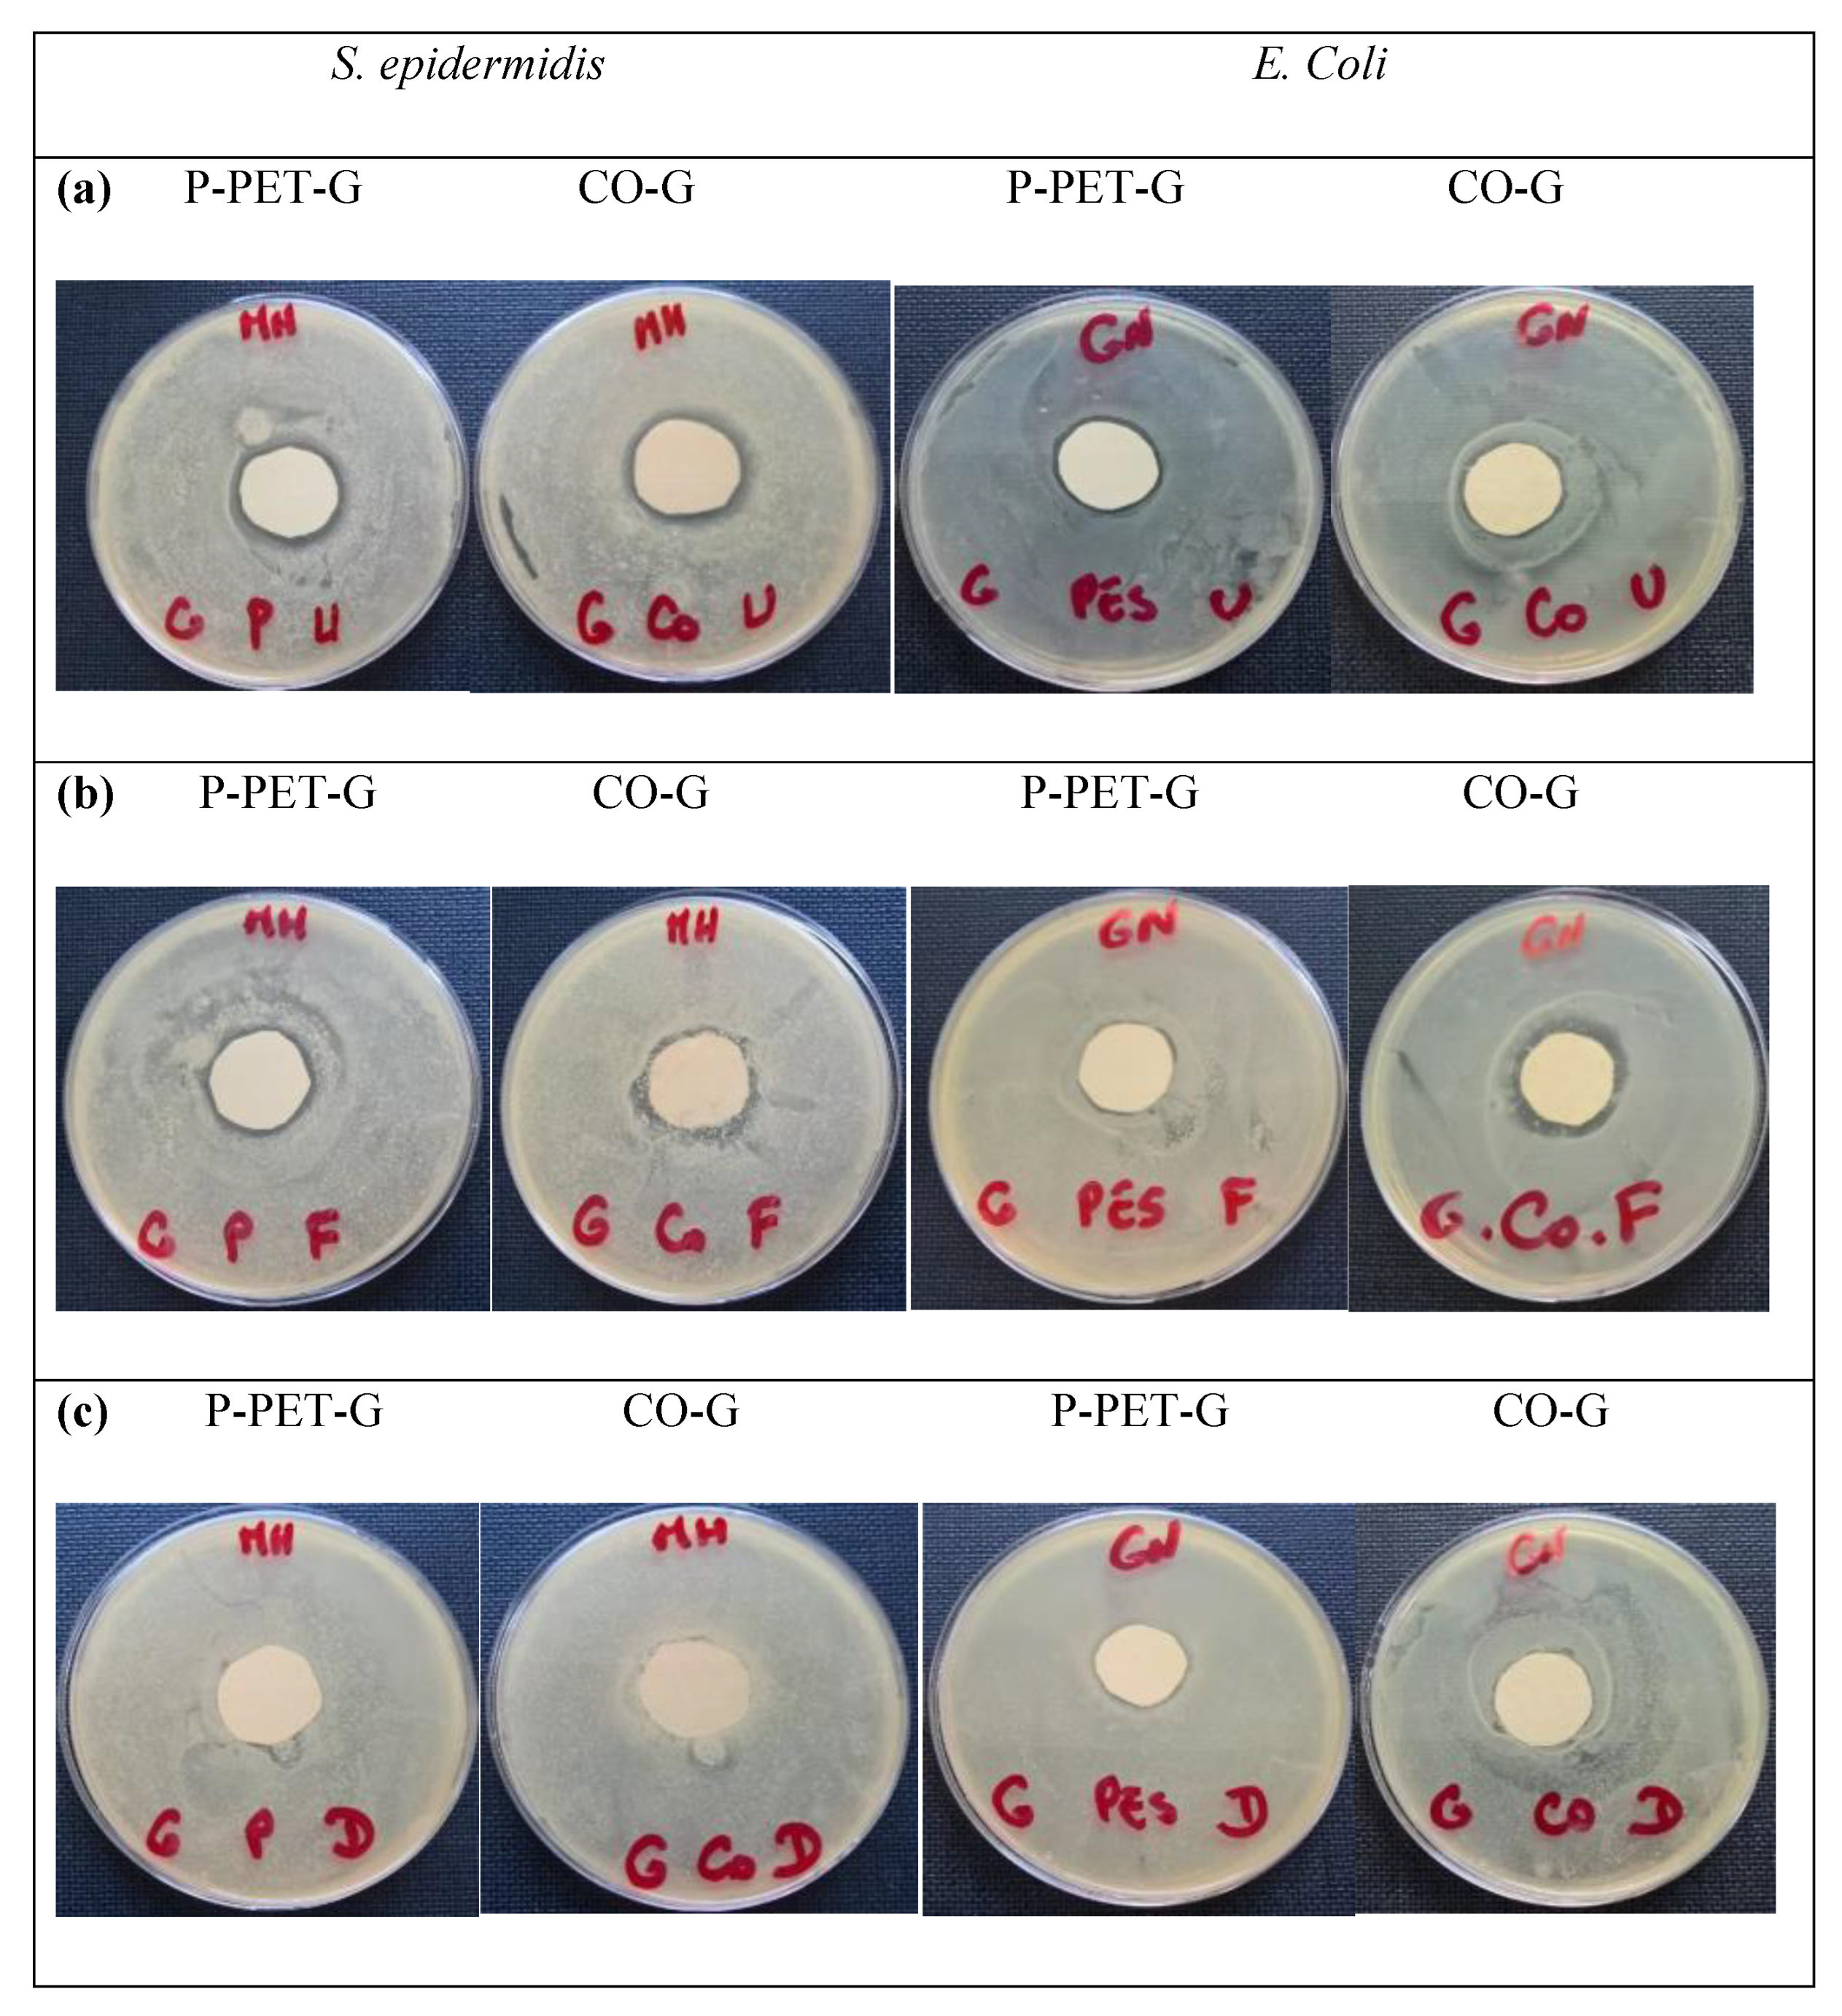
Polymers 15 01362 g010 Polymers 15 01362 g010

Assessing Alternative Pre-Treatment Methods to Promote Essential Oil Fixation into Cotton and Polyethylene Terephthalate Fiber: A Comparative Study
Abstract
1. Introduction
2. Materials and Methods
2.1. Materials
2.1.1. Air Atmospheric Plasma Treatment of PET Fabrics
- (i)
- First, PET fabric was cut and engrossed into the petroleum ether solution using Soxhlet for 5 h at 60 °C;
- (ii)
- Second, nonwovens were ultrasonically impregnated in absolute ethanol for 20 min followed by drying for 12 h. In this step, nonwovens were repeatedly ultrasonically washed with deionized water and dried three times;
- (iii)
- Third, the cleaned fabrics were activated by atmospheric air plasma, based on a dielectric barrier discharge (DBD), which was used to activate the PET surface. The treatment was carried out by the ”Coating Star” plasma treatment set-up provided by Ahlbrandt System (Lauterbach, Germany) as shown in Scheme 1. Atmospheric air was chosen as the gas, and the following parameters were used to treat the nonwoven on both sides: a frequency of 26 kHz, rotation speed of 2 m min−1, electrical power of 750 W, an inter-electrode distance of 1.5 mm, and a plasma treatment power of 60 kJ/m2. The following machine parameters, as shown in Table S1, were kept constant throughout the treatments of all samples. The plasma treated PET was denoted P-PET.
2.1.2. Ultrasound-Assisted Oil Absorption into Fabrics
2.1.3. Padding Method for Essential Oil Incorporation
2.1.4. Diffusion Method for Essential Oil Insertion
2.2. Surface Analysis
2.3. Color Strength
2.4. Solubility Parameters of the Geraniol Essential Oil and Polyester
2.5. Testing of Olfactory Function
2.6. Durability and Rub Fastness Test
2.7. Antibacterial Tests
3. Results
3.1. Effects of Solvent
3.2. Morphological Analysis
3.3. IR Evidences for GEO Fixation
3.4. Hydrophilic Character and Thermal Stability
3.5. Olfactory Properties of Treated Fabric
3.6. Color Strength Evidence of EO Absorption into Fabrics
3.7. Durability/Fastness Properties
3.8. Bacterial Susceptibility Testing to Antibiotics
4. Discussions
5. Conclusions
Supplementary Materials
Author Contributions
Funding
Institutional Review Board Statement
Data Availability Statement
Conflicts of Interest
References
- Cheng, S.Y.; Yuen, C.W.M.; Kan, C.W.; Cheuk, K.K.L.; Tang, J.C.O.; Li, S.Y. A comprehensive study of silicone-based cosmetic textile agent. Fibers Polym. 2009, 10, 132–140. [Google Scholar] [CrossRef]
- Holme, I. Innovative technologies for high performance textiles. Color. Technol. 2007, 123, 59–73. [Google Scholar] [CrossRef]
- Kathirvelu, S.; D’Souza, L.; Dhurai, B. UV protection finishing of textiles using ZnO nanoparticles. Indian J. Fibre Text. Res. 2009, 34, 267–273. [Google Scholar]
- Singh, M.K.; Singh, A. Ultraviolet Protection by Fabric Engineering. J. Text. 2013, 2013, 579129. [Google Scholar] [CrossRef]
- Alonso, C.; Martí, M.; Barba, C.; Lis, M.; Rubio, L.; Coderch, L. Skin penetration and antioxidant effect of cosmeto-textiles with gallic acid. J. Photochem. Photobiol. B Biol. 2016, 156, 50–55. [Google Scholar] [CrossRef]
- Kalagatur, N.K.; Nirmal Ghosh, O.S.; Sundararaj, N.; Mudili, V. Antifungal Activity of Chitosan Nanoparticles Encapsulated with Cymbopogon martinii Essential Oil on Plant Pathogenic Fungi Fusarium graminearum. Front. Pharmacol. 2018, 9, 610. [Google Scholar] [CrossRef]
- Kalagatur, N.K.; Mudili, V.; Kamasani, J.R.; Siddaiah, C. Discrete and combined effects of Ylang-Ylang (Cananga odorata) essential oil and gamma irradiation on growth and mycotoxins production by Fusarium graminearum in maize. Food Control. 2018, 94, 276–283. [Google Scholar] [CrossRef]
- Mainardi, T.; Kapoor, S.; Bielory, L. Complementary and alternative medicine: Herbs, phytochemicals and vitamins and their immunologic effects. J. Allergy Clin. Immunol. 2009, 123, 283–294.e210. [Google Scholar] [CrossRef]
- Amabeoku, G.J. Antidiarrhoeal activity of Geranium incanum Burm. f. (Geraniaceae) leaf aqueous extract in mice. J. Ethnopharmacol. 2009, 123, 190–193. [Google Scholar] [CrossRef]
- Elmann, A.; Mordechay, S.; Rindner, M.; Ravid, U. Anti-neuroinflammatory effects of geranium oil in microglial cells. J. Funct. Foods 2010, 2, 17–22. [Google Scholar] [CrossRef]
- Zhuang, S.-R.; Chen, S.-L.; Tsai, J.-H.; Huang, C.-C.; Wu, T.-C.; Liu, W.-S.; Tseng, H.-C.; Lee, H.-S.; Huang, M.-C.; Shane, G.-T.; et al. Effect of citronellol and the Chinese medical herb complex on cellular immunity of cancer patients receiving chemotherapy/radiotherapy. Phytother. Res. 2009, 23, 785–790. [Google Scholar] [CrossRef]
- Ibrahim, N.A.; Eid, B.M.; Abd El-Ghany, N.A.; Mabrouk, E.M. Polyfunctional cotton cellulose fabric using proper biopolymers and active ingredients. J. Text. Inst. 2020, 111, 381–393. [Google Scholar] [CrossRef]
- Ibrahim, N.A.; Eid, B.M.; Abdellatif, F.H.H. Advanced Materials and Technologies for Antimicrobial Finishing of Cellulosic Textiles. In Handbook of Renewable Materials for Coloration and Finishing; Yusuf, M., Ed.; Wiley-Scrivener: Beverly, MA, USA, 2018; Volume 13, pp. 303–356. [Google Scholar]
- Yuan, G.; Cranston, R. Recent Advances in Antimicrobial Treatments of Textiles. Text. Res. J. 2008, 78, 60–72. [Google Scholar] [CrossRef]
- Ibrahim, N.A.; Eid, B.M. Potential Applications Of Sustainable Polymers in Functionlization Cellulosic Textile Materials; CRC Press: Boca Raton, FL, USA, 2016. [Google Scholar]
- Ibrahim, N.A.; Eid, B.M. Plasma Treatment Technology for Surface Modification and Functionalization of Cellulosic Fabrics. In Advances in Functional Finishing of Textiles; Shahid, M., Adivarekar, R., Eds.; Springer Singapore: Singapore, 2020; pp. 275–287. [Google Scholar] [CrossRef]
- Chatha, S.A.S.; Asgher, M.; Asgher, R.; Hussain, A.I.; Iqbal, Y.; Hussain, S.M.; Bilal, M.; Saleem, F.; Iqbal, H.M.N. Environmentally responsive and anti-bugs textile finishes—Recent trends, challenges, and future perspectives. Sci. Total Environ. 2019, 690, 667–682. [Google Scholar] [CrossRef] [PubMed]
- Ibrahim, N.A.; Eid, B.M.; El-Zairy, E.R. Antibacterial functionalization of reactive-cellulosic prints via inclusion of bioactive Neem oil/βCD complex. Carbohydr. Polym. 2011, 86, 1313–1319. [Google Scholar] [CrossRef]
- Ibrahim, N.A.; El-Zairy, E.M.; Eid, B.M.; Abd Allah, S.S.; Emam, E.-A.M. Durable surface functionalisation and pigment coloration of cellulosic fabrics using bioactive additives. Color. Technol. 2021, 137, 645–657. [Google Scholar] [CrossRef]
- Tawiah, B.; Badoe, W.; Fu, S. Advances in the Development of Antimicrobial Agents for Textiles: The Quest for Natural Products. Review. Fibres Text. East. Eur. 2016, 24, 136–149. [Google Scholar] [CrossRef]
- Hu, J.L. 1—Introduction to active coatings for smart textiles. In Active Coatings for Smart Textiles; Hu, J., Ed.; Woodhead Publishing: Cambridgeshire, UK, 2016; pp. 1–7. [Google Scholar] [CrossRef]
- Specos, M.M.; García, J.J.; Tornesello, J.; Marino, P.; Vecchia, M.D.; Tesoriero, M.V.; Hermida, L.G. Microencapsulated citronella oil for mosquito repellent finishing of cotton textiles. Trans. R. Soc. Trop. Med. Hyg. 2010, 104, 653–658. [Google Scholar] [CrossRef]
- Morshed, M.N.; Pervez, M.N.; Behary, N.; Bouazizi, N.; Guan, J.; Nierstrasz, V.A. Statistical modeling and optimization of heterogeneous Fenton-like removal of organic pollutant using fibrous catalysts: A full factorial design. Sci. Rep. 2020, 10, 16133. [Google Scholar] [CrossRef]
- Fox, C.L., Jr.; Modak, S.M. Mechanism of silver sulfadiazine action on burn wound infections. Antimicrob. Agents Chemother. 1974, 5, 582–588. [Google Scholar] [CrossRef]
- Hansen, C.M. Hansen Solubility Parameters: A User’s Handbook, 2nd ed.; CRC Press: Boca Raton, FL, USA, 2007; p. 544. [Google Scholar]
- Abbott, S. Solubility Science: Principles and Practice. 2018. Available online: https://www.stevenabbott.co.uk/practical-solubility/the-book.php (accessed on 1 February 2023).
- Paseta, L.; Simón-Gaudó, E.; Gracia-Gorría, F.; Coronas, J. Encapsulation of essential oils in porous silica and MOFs for trichloroisocyanuric acid tablets used for water treatment in swimming pools. Chem. Eng. J. 2016, 292, 28–34. [Google Scholar] [CrossRef]
- Slark, A.T.; Hadgett, P.M. The effect of specific interactions on dye transport in polymers above the glass transition. Polymer 1999, 40, 4001–4011. [Google Scholar] [CrossRef]
- Bouazizi, N.; El Achari, A.; Campagne, C.; Vieillard, J.; Azzouz, A. Polyfunctional cotton fabrics with catalytic activity and antibacterial capacity. Chem. Eng. J. 2018, 351, 328–339. [Google Scholar] [CrossRef]
- Samavati, Z.; Samavati, A.; Ismail, A.F.; Yahya, N.; Rahman, M.A.; Othman, M.H.D. Effect of acetone/methanol ratio as a hybrid solvent on fabrication of polymethylmethacrylate optical fiber sensor. Opt. Laser Technol. 2020, 123, 105896. [Google Scholar] [CrossRef]
- Southwell, I.A.; Stiff, I.A. Chemical Composition of an Australian Geranium Oil. J. Essent. Oil Res. 1995, 7, 545–547. [Google Scholar] [CrossRef]
- Yoon, H.; Kim, H.; Latthe, S.S.; Kim, M.-W.; Al-Deyab, S.; Yoon, S.S. A highly transparent self-cleaning superhydrophobic surface by organosilane-coated alumina particles deposited via electrospraying. J. Mater. Chem. A 2015, 3, 11403–11410. [Google Scholar] [CrossRef]
- Szejtli, J. Introduction and General Overview of Cyclodextrin Chemistry. Chem. Rev. 1998, 98, 1743–1754. [Google Scholar] [CrossRef]
- Kayaci, F.; Umu, O.C.O.; Tekinay, T.; Uyar, T. Antibacterial Electrospun Poly(lactic acid) (PLA) Nanofibrous Webs Incorporating Triclosan/Cyclodextrin Inclusion Complexes. J. Agric. Food Chem. 2013, 61, 3901–3908. [Google Scholar] [CrossRef]
- Zhang, C.; Zhao, M.; Wang, L.; Qu, L.; Men, Y. Surface modification of polyester fabrics by atmospheric-pressure air/He plasma for color strength and adhesion enhancement. Appl. Surf. Sci. 2017, 400, 304–311. [Google Scholar] [CrossRef]
- Mishra, A.; Butola, B.S. Deposition of Ag doped TiO2 on cotton fabric for wash durable UV protective and antibacterial properties at very low silver concentration. Cellulose 2017, 24, 3555–3571. [Google Scholar] [CrossRef]
- Zhang, Z.; Zhao, Z.; Zheng, Z.; Liu, S.; Mao, S.; Li, X.; Chen, Y.; Mao, Q.; Wang, L.; Wang, F.; et al. Functionalization of polyethylene terephthalate fabrics using nitrogen plasma and silk fibroin/chitosan microspheres. Appl. Surf. Sci. 2019, 495, 143481. [Google Scholar] [CrossRef]
- Ohl, S.W.; Klaseboer, E.; Khoo, B.C. Bubbles with shock waves and ultrasound: A review. Interface Focus 2015, 5, 20150019. [Google Scholar] [CrossRef] [PubMed]

| Ultrasound | Padding | Diffusion | |||
|---|---|---|---|---|---|
| Solvent | Methanol | Ethanol | Methanol | Ethanol | Ethanol + Water |
| Time (min) | 30 | 30 | ≈10 | ≈10 | 240 |
| Temperature (°C) | 50 | 50 | 30 | 30 | 90–130 |
| Consumed water (mL) | 0 | 0 | 200 | 200 | 140 |
| Consumed energy (kJ) | 576 | 15 | 4140 | ||
| Efficiency on GEO fixation | Excellent | Excellent | Average | Average | Low |
| Solubility Parameter (MPa1/2) | Thermal Stability (°C) | |||||
|---|---|---|---|---|---|---|
| δd | δp | δh | δt | Range of Degradation | Max. Stability | |
| Geraniol | 16.9 | 4.2 | 7.6 | 19 | 80–215 | 153 |
| PET | 18.2 | 7.3 | 7.9 | 21.4 | 310–450 | 280 |
| Samples | Contact Angle (°) * | ||
|---|---|---|---|
| Ultrasound | Padding | Diffusion | |
| PET | 89.95 | 89.95 | 89.95 |
| PET—G | 73.05 | 73.51 | 72.74 |
| CO | 73.35 | 73.35 | 73.35 |
| CO—G | 73.80 | 73.62 | 72.97 |
| Treatments Method | Samples | Mass Loss (wt. %) | Odour Intensity | Color Strength (K/S) | Color Fastness to Washing Grades ** | |
|---|---|---|---|---|---|---|
| 78.24 * | 416.32 * | |||||
| Ultrasound | P—PET | 98.77 | -- | None | 0.52 | -- |
| P—PET—G | 98.58 | 89.06 | Average-very good | 0.91 | 0.63 | |
| CO | 95.12 | 18.02 | None | 0.22 | -- | |
| CO—G | 92.92 | 19.28 | Good-excellent | 0.79 | 0.45 | |
| Padding | P—PET | 98.77 | -- | None | 0.52 | -- |
| P—PET—G | -- | -- | Low-average | 0.81 | 0.57 | |
| CO | 95.12 | 18.02 | None | 0.17 | -- | |
| CO—G | -- | -- | Low-good | 0.56 | 0.40 | |
| Diffusion | P—PET | 98.77 | -- | None | 0.52 | -- |
| P—PET—G | -- | -- | Very low-low | 0.77 | 0.62 | |
| CO | 95.12 | 18.02 | None | 0.22 | -- | |
| CO—G | -- | -- | Very low-low | 0.50 | 0.34 | |
| Methods | Zone of Inhibition (mm) | |||||||
|---|---|---|---|---|---|---|---|---|
| E. coli | S. epidermidis | |||||||
| CO | CO—G | P—PET | P—PET—G | CO | CO—G | P—PET | P—PET—G | |
| Ultrasound | 0 | 3.9 | ~0 | 3 | ~0 | 3.4 | ~0 | 2.7 |
| Padding | 0 | 2 | ~0 | 1 | ~0 | 1.5 | ~0 | 0.5 |
| Diffusion | 0 | ~0 | ~0 | 0.1 | ~0 | 0.4 | ~0 | 0.1 |
Disclaimer/Publisher’s Note: The statements, opinions and data contained in all publications are solely those of the individual author(s) and contributor(s) and not of MDPI and/or the editor(s). MDPI and/or the editor(s) disclaim responsibility for any injury to people or property resulting from any ideas, methods, instructions or products referred to in the content. |
© 2023 by the authors. Licensee MDPI, Basel, Switzerland. This article is an open access article distributed under the terms and conditions of the Creative Commons Attribution (CC BY) license (https://creativecommons.org/licenses/by/4.0/).
Share and Cite
Tansaoui, H.; Bouazizi, N.; Behary, N.; Campagne, C.; El-Achari, A.; Vieillard, J. Assessing Alternative Pre-Treatment Methods to Promote Essential Oil Fixation into Cotton and Polyethylene Terephthalate Fiber: A Comparative Study. Polymers 2023, 15, 1362. https://doi.org/10.3390/polym15061362
Tansaoui H, Bouazizi N, Behary N, Campagne C, El-Achari A, Vieillard J. Assessing Alternative Pre-Treatment Methods to Promote Essential Oil Fixation into Cotton and Polyethylene Terephthalate Fiber: A Comparative Study. Polymers. 2023; 15(6):1362. https://doi.org/10.3390/polym15061362
Chicago/Turabian StyleTansaoui, Hanane, Nabil Bouazizi, Nemeshwaree Behary, Christine Campagne, Ahmida El-Achari, and Julien Vieillard. 2023. "Assessing Alternative Pre-Treatment Methods to Promote Essential Oil Fixation into Cotton and Polyethylene Terephthalate Fiber: A Comparative Study" Polymers 15, no. 6: 1362. https://doi.org/10.3390/polym15061362
APA StyleTansaoui, H., Bouazizi, N., Behary, N., Campagne, C., El-Achari, A., & Vieillard, J. (2023). Assessing Alternative Pre-Treatment Methods to Promote Essential Oil Fixation into Cotton and Polyethylene Terephthalate Fiber: A Comparative Study. Polymers, 15(6), 1362. https://doi.org/10.3390/polym15061362

